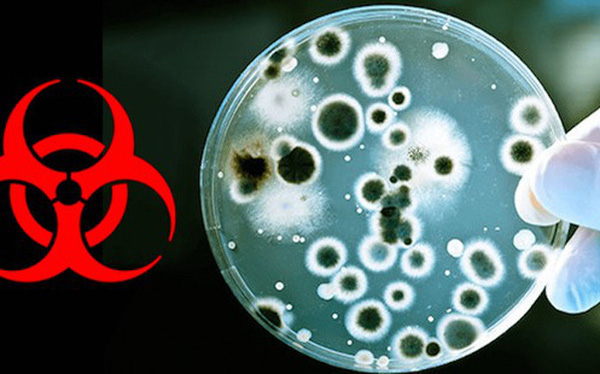
Nhà khoa học Vũ Hán: TQ không chế tạo và thêm HIV vào virus corona, đây là sự trừng phạt của thiên nhiên - Ảnh 1. Nhà khoa học Vũ Hán: TQ không chế tạo và thêm HIV vào virus corona, đây là sự trừng phạt của thiên nhiên - Ảnh 1.

Nhà khoa học Vũ Hán: TQ không "chế tạo" và thêm HIV vào virus corona, đây là "sự trừng phạt của thiên nhiên"
Một nhà khoa học tại Viện Virus học Vũ Hán đã lên tiếng bác bỏ thuyết âm mưu cho rằng virus corona 2019-nCoV được Trung Quốc "chế tạo" và đã thoát khỏi cơ sở nghiên cứu ở Vũ Hán.
- Hãng sản xuất chip ở Vũ Hán tự tin duy trì hoạt động bình thường bất chấp đại dịch viêm phổi cấp
- Hình ảnh mới nhất về hai bệnh viện dã chiến sắp hoàn tất ở Vũ Hán: "Thời gian là mạng sống. Chúng tôi đang chạy đua với cái chết!"
- Cuộc sống của một phóng viên công nghệ “mắc kẹt” tại tâm dịch viêm phổi Vũ Hán
China Daily dẫn lời Shi Zhengli, một nhà nghiên cứu tại Viện Virus học Vũ Hán , khẳng định: "Virus corona tại Vũ Hán là sự trừng phạt của thiên nhiên đối với lối sinh hoạt không văn minh của con người. Tôi xin thề bằng cả tính mạng mình rằng virus này không liên quan tới phòng thí nghiệm Vũ Hán".
Được biết, Shi là nhà khoa học chỉ đạo nhóm nghiên cứu phát hiện ra rằng có thể virus corona xuất phát từ loài dơi. Lời bình luận này được đưa ra sau khi các nhà khoa học Ấn Độ công bố một bài viết cho rằng "ai đó" đã thêm gen của virus HIV vào virus corona, và minh chứng rõ ràng nhất là virus corona yếu đi khi bệnh nhân được điều trị bằng thuốc chữa HIV.
Ngay sau khi đăng tải, bài viết đã bị giới chuyên gia trên khắp thế giới chỉ trích kịch liệt và đã bị gỡ khỏi trang bioRxiv, một trang chuyên về tạp chí nghiên cứu sinh học.
Trong một bài bình luận, David Liu, một giáo sư hóa học tại Đại học Harvard, cho biết: "Lời cáo buộc cho rằng 'virus corona Vũ Hán không xuất hiện từ tự nhiên' là rất sai lầm. Thế giới ngày nay không cần thêm những thuyết âm mưu từ những phân tích tồi tệ nữa".
Bài viết của một số nhà khoa học Ấn Độ đã được hàng loạt kênh thông tin đăng tải lại, cho rằng các nhà khoa học Trung Quốc đã chế tạo ra virus corona chủng mới và nó đã thoát khỏi phòng thí nghiệm có mức độ an toàn sinh học cấp 4 - cấp cao nhất theo tiêu chuẩn nguy hiểm sinh học và được cấp phép để nghiên cứu những chủng virus nguy hiểm nhất thế giới, bao gồm Ebola, dịch đậu mùa, sốt Lassa và virus Marburg.
Thuyết âm mưu này bắt đầu vào cuối tháng 1 khi tờ Daily Mail (Anh) và tờ Washington Times (Mỹ) đăng các bài viết cho rằng dịch viêm phổi Vũ Hán bùng phát là do kết quả của nghiên cứu vũ khí sinh học bí mật tại Trung Quốc.
Mặc dù các bài viết không đưa ra bằng chứng cụ thể nhưng thuyết âm mưu nói trên nhanh chóng thu hút được nhiều sự chú ý của người dùng mạng xã hội. Những trang báo khác như BBC và Foreign Policy đã lên tiếng phản đối giả thuyết này.
Ngày 28/1, Đại sứ quán Trung Quốc tại Italy khẳng định thuyết âm mưu là vô căn cứ, đưa tin sai.
NỔI BẬT TRANG CHỦ
-
Cũng dùng một loạt iPhone để quay, album trailer “HVL” của đạo diễn Việt khác gì bom tấn điện ảnh 28 Years Later?
Một công cụ, hai cách tiếp cận: album trailer “HVL” và 28 Years Later cho thấy sự khác biệt không đến từ thiết bị, mà từ cách nó được sử dụng.
-
Apple và MCK hợp tác thực hiện album trailer 360 độ quay bằng 8 chiếc iPhone 17 Pro